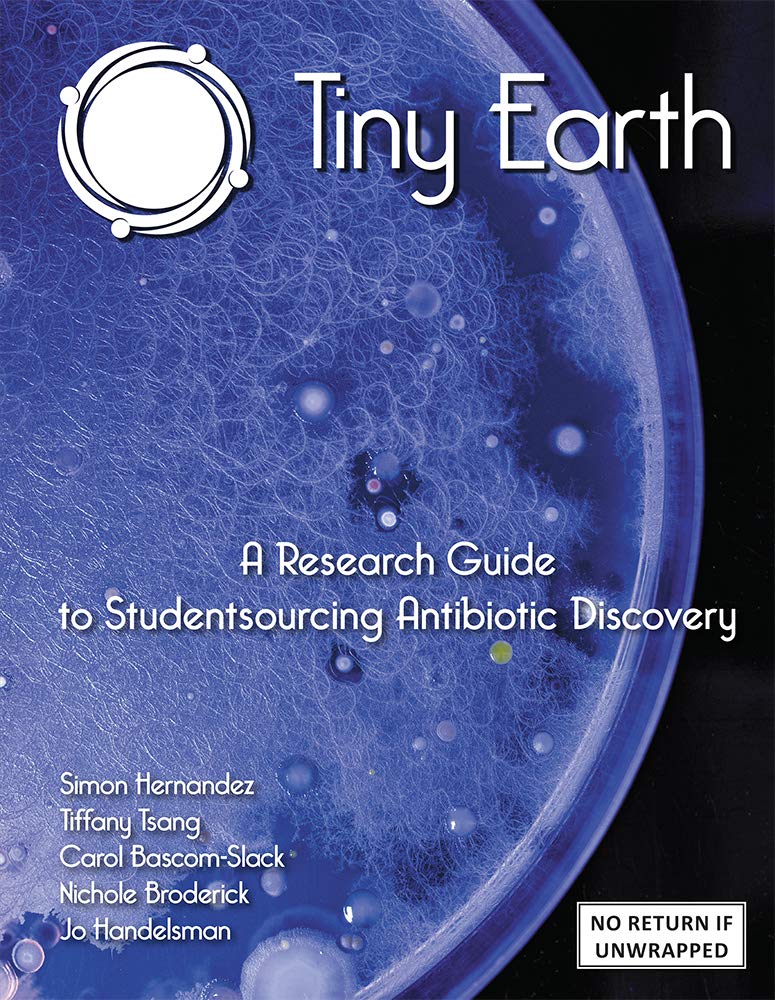

Title
Tiny Earth A Research Guide to Studentsourcing Antibiotic Discovery (Print plus FULL eBook access), Revised Edition, 2021,New
Delivery time: 8-12 business days (International)
Tiny Earth is a network of instructors and students focused on crowdsourcing antibiotic discovery from soil. This book is a Research Guide to Studentsourcing Antibiotic Discovery, and it includes the printed book plus digital access to an eBook version.The challenges are huge...Today we are fighting a shortage of effective antibiotics as superbugs evolve resistance to our mostused antibiotics. Simultaneously, we face a shortage of science trainees as unengaging introductory science courses fail to retain some of the best and brightest students in STEM fields.But the solutions start tiny.Unearthing new antibioticproducing microbes from the soil can address a worldwide health threat while inspiring students to pursue careers in science. Tiny Earth brings the potential for global impact through original laboratory and field research conducted in introductory courses. Tiny Earth is a network of instructors and students focused on crowdsourcing antibiotic discovery from soil.The mission of the program is twofold:First, it seeks to inspire students to pursue careers in science through original laboratory and field research conducted in introductory courses with the potential for global impact. Second, it aims to address a worldwide health threat the diminishing supply of effective antibiotics by tapping into the collective power of many student researchers concurrently tackling the same challenge, living up to its motto 'studentsourcing antibiotic discovery'.Tiny Earth is a global network of students and instructors conducting research on soil and antibiotics.The network has four goals:1. Educate students about the antibiotic crisis.2. Educate students about the soil crisis.3. Engage students in original scientific research.4. Discover new antibiotics from soil!
By changing our most important processes and
products, we have already made a big leap forward. This ranges from the
increased use of more sustainable fibers to the use of more
environmentally friendly printing processes to the development of
efficient waste management in our value chain.
Shipping & Returns
Shipping
We ship your order within 2–3 business days for USA deliveries and 5–8 business days for international shipments. Once your package has been dispatched from our warehouse, you'll receive an email confirmation with a tracking number, allowing you to track the status of your delivery.
Returns
To facilitate a smooth return process, a Return Authorization (RA) Number is required for all returns. Returns without a valid RA number will be declined and may incur additional fees. You can request an RA number within 15 days of the original delivery date. For more details, please refer to our Return & Refund Policy page.
Shipping & Returns
Shipping
We ship your order within 2–3 business days for USA deliveries and 5–8 business days for international shipments. Once your package has been dispatched from our warehouse, you'll receive an email confirmation with a tracking number, allowing you to track the status of your delivery.
Returns
To facilitate a smooth return process, a Return Authorization (RA) Number is required for all returns. Returns without a valid RA number will be declined and may incur additional fees. You can request an RA number within 15 days of the original delivery date. For more details, please refer to our Return & Refund Policy page.
Warranty
We provide a 2-year limited warranty, from the date of purchase for all our products.
If you believe you have received a defective product, or are experiencing any problems with your product, please contact us.
This warranty strictly does not cover damages that arose from negligence, misuse, wear and tear, or not in accordance with product instructions (dropping the product, etc.).
Warranty
We provide a 2-year limited warranty, from the date of purchase for all our products.
If you believe you have received a defective product, or are experiencing any problems with your product, please contact us.
This warranty strictly does not cover damages that arose from negligence, misuse, wear and tear, or not in accordance with product instructions (dropping the product, etc.).
Secure Payment
Your payment information is processed securely. We do not store credit card details nor have access to your credit card information.
We accept payments with :
Visa, MasterCard, American Express, Paypal, Shopify Payments, Shop Pay and more.
Secure Payment
Your payment information is processed securely. We do not store credit card details nor have access to your credit card information.
We accept payments with :
Visa, MasterCard, American Express, Paypal, Shopify Payments, Shop Pay and more.